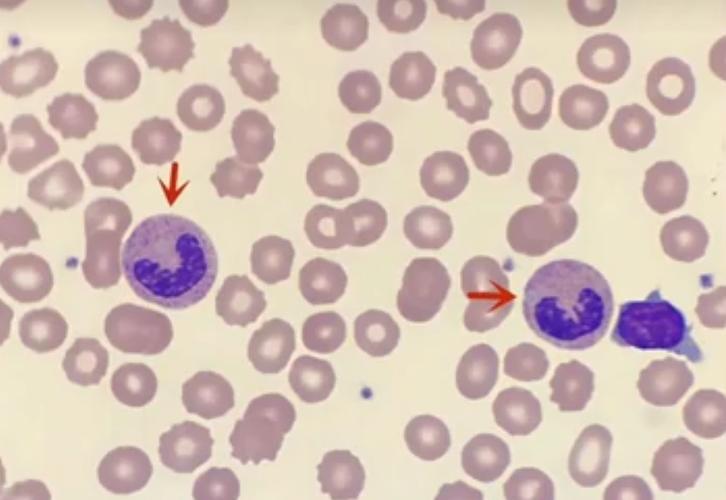
孕期中性粒细胞比率高-第2张图片-郑州医学网 孕期中性粒细胞比率高-第2张图片-郑州医学网

下面我将为您详细解释孕期中性粒细胞比率偏高的可能原因、需要关注什么,以及应该怎么做。

我们来了解一下基本概念
- 中性粒细胞 (Neutrophil):是白细胞的一种,是人体免疫系统中最主要的“卫士”,它们负责对抗细菌、真菌等病原体入侵,是身体抵抗感染的第一道防线。
- 中性粒细胞比率 (Neutrophilic Granulocyte %):指在中性粒细胞占所有白细胞总数的百分比。
- 孕期生理变化:怀孕后,为了适应胎儿的生长和发育,母体的血液系统会发生一系列显著变化,其中就包括白细胞总数的生理性增高。
孕期中性粒细胞比率偏高的主要原因
生理性增高(最常见,通常无需担心)
这是孕期最常见的原因,属于正常的生理适应性变化。
-
原因:
- 激素影响:怀孕期间,胎盘会分泌大量的激素,如人绒毛膜促性腺激素、孕激素、雌激素等,这些激素可以刺激骨髓制造更多的白细胞,其中中性粒细胞增加最为显著。
- 免疫耐受:母体需要接受一半来自父系的胎儿,免疫系统处于一种特殊的“耐受”状态,但这种状态也伴随着免疫系统的适度激活,可能导致白细胞总数和分类比例的变化。
- 血液稀释效应:孕期血容量会增加,但红细胞的增加速度不如血浆快,导致血液相对稀释,但白细胞的增加更为明显,所以其绝对值和比例都可能升高。
-
特点:
- 通常在孕中晚期(孕12周后)开始出现,并随着孕周增加而逐渐升高。
- 一般没有其他伴随症状。
- 中性粒细胞绝对值(Absolute Neutrophil Count, ANC)通常在6.0 - 10.0 x 10⁹/L之间,很少会超过这个范围。
- 其他血常规指标(如红细胞、血小板)基本正常。
病理性增高(需要警惕)
如果中性粒细胞比率显著升高,或者伴有其他症状,则可能提示存在某些病理情况。
-
感染(最常见的原因):
- 部位:可能是上呼吸道感染(感冒、咽炎)、泌尿系统感染(孕期非常常见)、生殖道感染、牙龈炎等。
- 特点:除了中性粒细胞比率升高,通常还会伴有白细胞总数显著升高,并且患者有相应的症状,如发烧、咳嗽、尿频尿急、疼痛等。
-
妊娠期特有疾病:
- 绒毛膜羊膜炎:常与胎膜早破相关,是导致产褥感染和新生儿感染的重要原因,除了中性粒细胞升高,还可能伴有母体和(或)胎儿心率增快、子宫压痛、羊水有异味等。
- 重度子痫前期/HELLP综合征:这是一种严重的妊娠并发症,可能伴有微血管内溶血和血小板减少,导致炎症反应加剧,中性粒细胞升高。
-
其他非孕期原因:
- 应激状态:如剧烈疼痛、精神紧张、大手术、外伤等。
- 血液系统疾病:如白血病、骨髓增殖性肿瘤等,但这类疾病通常中性粒细胞会极度升高,并伴有贫血、血小板异常等其他血象改变,非常罕见。
应该怎么办?—— 医生的处理思路
当您的血常规报告显示中性粒细胞比率偏高时,医生通常会按照以下步骤进行判断和处理:

-
看中性粒细胞绝对值:这是最关键的一步,医生会优先看“中性粒细胞绝对值”这个指标,如果只是轻度升高(如<10.0 x 10⁹/L),而其他指标正常,医生首先会考虑生理性可能。
-
结合临床症状:医生会仔细询问您是否有任何不适症状,
- 是否有发烧、寒战?
- 是否有咳嗽、咳痰、喉咙痛?
- 是否有尿频、尿急、尿痛?
- 是否有阴道分泌物增多、瘙痒或异味?
- 是否有腹痛?
- 是否有其他不适?
-
结合孕周和其他检查:
- 孕周:孕早期轻度升高可能更倾向于感染,而孕中晚期则生理性可能性大。
- 其他血常规指标:白细胞总数、淋巴细胞、单核细胞、红细胞、血小板等是否正常。
- 其他辅助检查:如果怀疑感染,可能会建议做尿常规、C反应蛋白(CRP)等检查来帮助判断,如果怀疑妊娠特有疾病,会监测血压、尿蛋白等。
给准妈妈的建议
-
不要自行恐慌:首先要明白,孕期中性粒细胞轻度升高非常普遍,多数情况下是正常的生理反应。
-
认真阅读报告:拿到血常规报告,除了看“中性粒细胞比率”,更要看“中性粒细胞绝对值”和“白细胞总数”,把这些数据带给医生看。
-
观察自身症状:留意自己是否有任何不适,如果没有发烧、疼痛等明显症状,那么生理性可能性很大。
-
与医生充分沟通:将您的所有疑问和担忧都告诉医生,医生会根据您的具体情况(孕周、症状、整体检查结果)给出最专业的判断。
-
保持良好生活习惯:
- 均衡饮食:保证营养,多吃富含蛋白质和维生素的食物。
- 充足休息:避免过度劳累,保证睡眠。
- 注意个人卫生:勤洗手,保持外阴清洁,预防感染。
- 多喝水:有助于预防泌尿系统感染。
孕期中性粒细胞比率偏高,绝大多数情况下是正常的生理现象,是身体为保护你和宝宝而做的积极调整。
只有当中性粒细胞绝对值显著升高,并且伴有发烧、疼痛等感染症状,或怀疑有妊娠期并发症时,才需要引起重视并进行进一步的检查和治疗。
最重要的一步是:将您的血常规报告和所有情况咨询您的产科医生,由医生来判断是否需要处理以及如何处理。 不要因为一个指标的轻微波动而过度焦虑,相信您的医生,也相信您身体的智慧,祝您孕期顺利!
标签: 孕期中性粒细胞偏高原因 孕期中性粒细胞比值高怎么办 孕晚期中性粒细胞比率升高